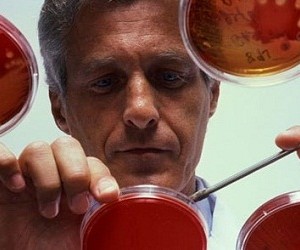

Искусственный костный мозг позволяет выращивать стволовые клетки крови
Гематопоэтические стволовые клетки в лабораторных условиях не будут терять своих стволовых свойств, если «производить» их в полимерном аналоге костного мозга вместе с клетками поддержки и соответствующими белками.
Клетки крови, будь то эритроциты или иммунные клетки, постоянно меняются: на место старых приходят новые, и происходит это за счёт стволовых гематопоэтических клеток. Эти стволовые клетки часто оказываются последней надеждой людей с заболеваниями крови: скажем, при лейкемии больные клетки можно заменить на здоровые с помощью гематопоэтических клеток от подходящего донора.
Но стволовые клетки крови живут в организме не сами по себе, а в костном мозге, причём пути их дифференцировки зависят от того, какую нишу они занимают в этом убежище. Следовательно, когда речь идёт о лечении гематопоэтическими клетками, обычно подразумевают пересадку костного мозга. Однако это не всегда возможно, и не для всякой лейкемии этого будет достаточно. В таких случаях очень помогли бы стволовые клетки, которые можно было бы выращивать и размножать искусственно, но, к сожалению, они в этом сильно зависят от костного мозга, без которого их развитие может пойти куда угодно, только не по нужному пути.
Сам костный мозг выглядит как пористая, губчатая структура, в которой, словно в корабельных доках, сидят стволовые клетки. Тут они не только прикреплены к определённому месту и получают питание и кислород, они ещё и активно обмениваются сигнальными молекулами с другими клетками, которые следят за созреванием клеток крови.
В общем, можно себе представить, насколько сложную структуру представляет собой костный мозг, а потому нельзя не подивиться на работу Корнелии Ли-Тедик (Cornelia Lee-Thedieck) из Технологического института Карлсруэ (Германия) и её коллег из Общества Макса Планка и других научных центров Германии. Учёным удалось создать искусственный костный мозг из специального полимера-гидрогеля, который образовывал такую же губчатую, пористую структуру, что и настоящий костный мозг. Клеточную составляющую в нём сделали за счёт мезенхимальных стволовых клеток из костного мозга и пуповины и гематопоэтических клеток из крови пуповины. Кроме того, в матрикс искусственного костного мозга добавлялись белки, которые в обычном костном мозге служат якорями, удерживающими стволовые клетки в их «доках».
Целью было заставить гематопоэтические клетки делиться, давая новые поколения стволовых клеток, то есть чтобы их популяция сама себя поддерживала. И, как пишут авторы работы в журнале Biomaterials, это вполне удалось. В таком искусственном окружении гематопоэтические клетки не только размножались несколько дней, но и сохраняли свои стволовые качества, то есть новые поколения могли также превращаться в специализированные кровяные клетки.
Большую роль тут сыграли, во-первых, мезенхимальные стволовые клетки (видимо, опекавшие стволовые), а во-вторых, то, что клетки росли в трёхмерной среде искусственной костномозговой массы, а не в виде плоской культуры. Очевидно, важность третьего измерения для полноценного существования клеток нужна не только тогда, когда мы «лепим» какой-то искусственный орган, но и для клеток крови, которые после созревания никакого оформленного органа не образуют, а отправляются плавать по кровяным, так сказать, просторам.
Что же до значения этой работы, то тут можно говорить не только о клинической практике (искусственный костный мозг позволит выращивать столько стволовых клеток, сколько нужно больному), но и о каких-то фундаментальных исследованиях — ведь с помощью такой модели можно глубже заглянуть в тайны биологии стволовых клеток вообще и стволовых клеток крови в частности.
Читайте также:
- Ухудшение зрения и боль в мышцах могут указывать на густую кровь
- Питание при повышенном сахаре: разрешённые и запрещённые продукты
- Соки для здоровья и очищения крови
- Как специи помогают очищать кровь и укреплять сосуды
- Тибетская медицина: 3 проверенных средства для чистой крови
- Упражнения, которые активизируют обменные процессы в крови

















Присоединяйтесь к нам в социальных сетях